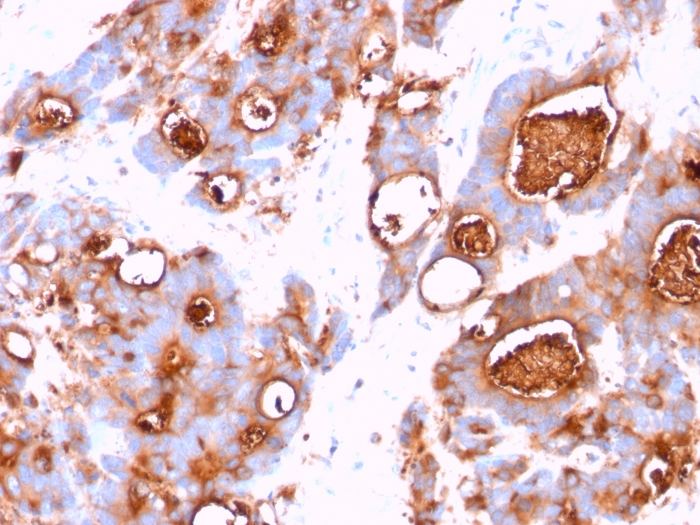

Formalin-fixed, paraffin-embedded human colon carcinoma stained with CEA Mouse Monoclonal Antibody (CEA31).
Formalin-fixed, paraffin-embedded human colon carcinoma stained with CEA Mouse Monoclonal Antibody (CEA31).
This antibody recognizes proteins of 80-200kDa, identified as different members of CEA family. CEA is synthesized during development in the fetal gut and is re-expressed in increased amounts in intestinal carcinomas and several other tumors. This MAb does not react with nonspecific cross-reacting antigen (NCA) and with human polymorphonuclear leucocytes. It shows no reaction with a variety of normal tissues and is suitable for staining of formalin/paraffin tissues. CEA is not found in benign glands, stroma, or malignant prostatic cells. Antibody to CEA is useful in detecting early foci of gastric carcinoma and in distinguishing pulmonary adenocarcinomas (60-70% are CEA+) from pleural mesotheliomas (rarely or weakly CEA+). Anti-CEA positivity is seen in adenocarcinomas from the lung, colon, stomach, esophagus, pancreas, gallbadder, urachus, salivary gland, ovary, and endocervix.
There are no reviews yet.